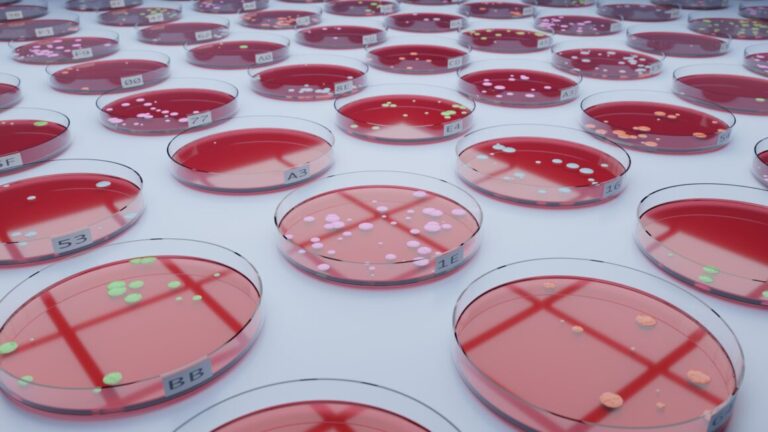

Diese Seite enthält medizinische und pharmazeutische Inhalte für medizinische Fachkreise, die nur diesen zugänglich sein darf. Bitte loggen Sie sich ein oder erstellen Sie ein Konto.
Diese Seite enthält medizinische und pharmazeutische Inhalte für medizinische Fachkreise, die nur diesen zugänglich sein darf. Bitte loggen Sie sich ein oder erstellen Sie ein Konto.
Diese Seite enthält medizinische und pharmazeutische Inhalte für medizinische Fachkreise, die nur diesen zugänglich sein darf. Bitte loggen Sie sich ein oder erstellen Sie ein Konto.
Diese Seite enthält medizinische und pharmazeutische Inhalte für medizinische Fachkreise, die nur diesen zugänglich sein darf. Bitte loggen Sie sich ein oder erstellen Sie ein Konto.
Diese Seite enthält medizinische und pharmazeutische Inhalte für medizinische Fachkreise, die nur diesen zugänglich sein darf. Bitte loggen Sie sich ein oder erstellen Sie ein Konto.
Diese Seite enthält medizinische und pharmazeutische Inhalte für medizinische Fachkreise, die nur diesen zugänglich sein darf. Bitte loggen Sie sich ein oder erstellen Sie ein Konto.
Diese Seite enthält medizinische und pharmazeutische Inhalte für medizinische Fachkreise, die nur diesen zugänglich sein darf. Bitte loggen Sie sich ein oder erstellen Sie ein Konto.
Diese Seite enthält medizinische und pharmazeutische Inhalte für medizinische Fachkreise, die nur diesen zugänglich sein darf. Bitte loggen Sie sich ein oder erstellen Sie ein Konto.
Diese Seite enthält medizinische und pharmazeutische Inhalte für medizinische Fachkreise, die nur diesen zugänglich sein darf. Bitte loggen Sie sich ein oder erstellen Sie ein Konto.
Diese Seite enthält medizinische und pharmazeutische Inhalte für medizinische Fachkreise, die nur diesen zugänglich sein darf. Bitte loggen Sie sich ein oder erstellen Sie ein Konto.